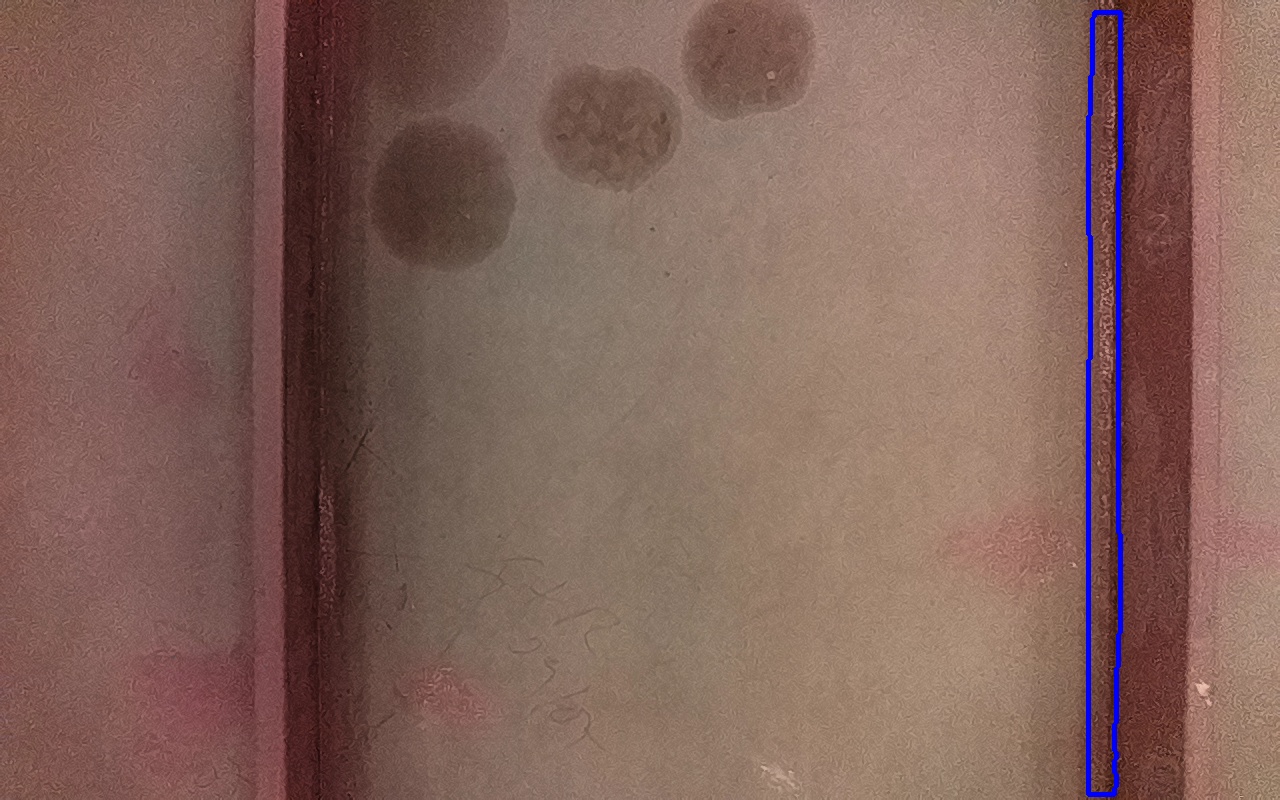

Discontinuidad detectada
| Tipo |
SOLD
Soldaduras y áreas adyacentes |
|---|---|
| Fecha | 27/06/2025 10:07 |
| Tamaño (mm) | 14929 mm2 |
| Tamaño (m) | 0.0149 m2 |
| Confianza | 31.69 % |
| Posición |
X: 2.63 Y: -0.46 Z: 0.03 |
| Resultado | Sin datos ToF |